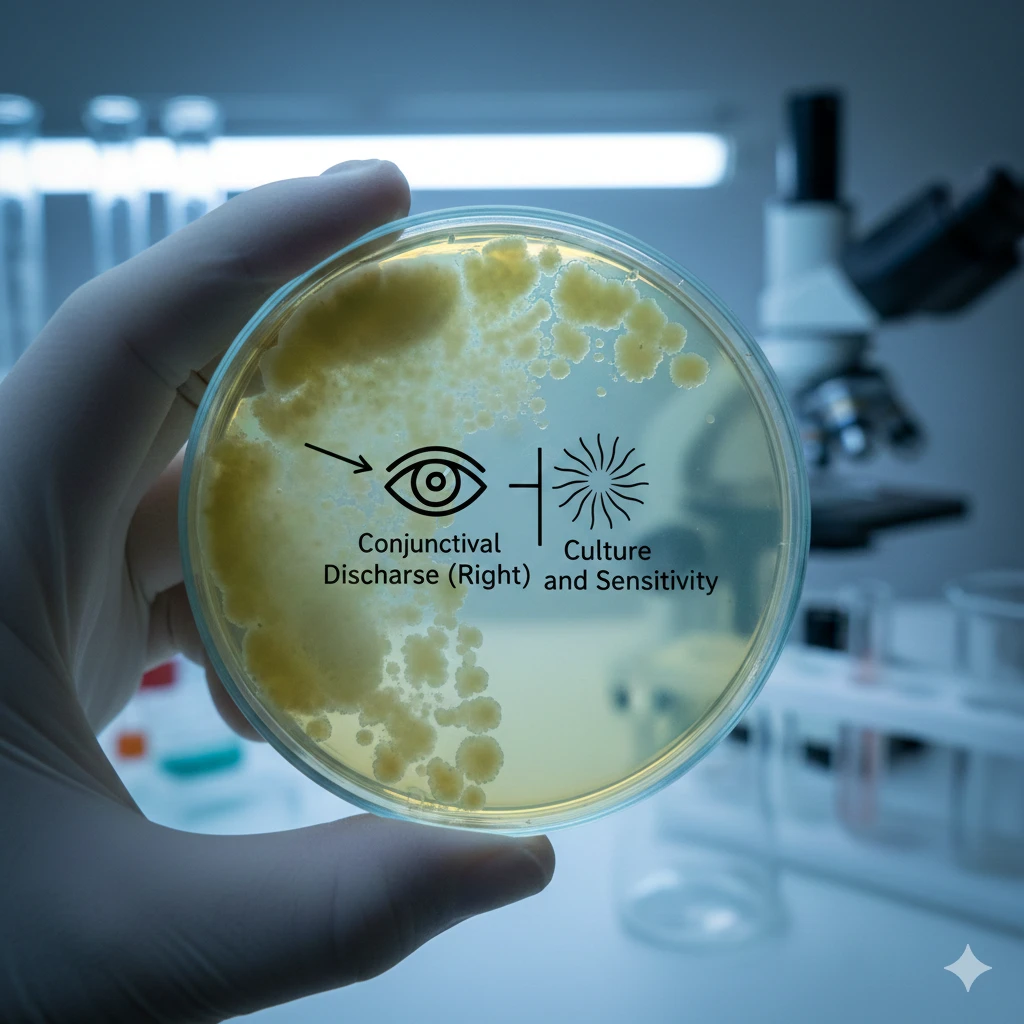
Conjunctival Discharge (Right) Culture and Sensi- tivity

تفاصيل التحليل
Conjunctival Discharge (Right) Culture and Sensi- tivity
هل تعاني عينك اليمنى من احمرار وإفرازات غير طبيعية؟ قد تكون العدوى البكتيرية هي السبب. هذا التحليل المخصص للعين اليمنى يأخذ عينة من الإفرازات لتحديد البكتيريا المسببة بدقة، ويختبر المضاد الحيوي الأمثل للقضاء عليها. يتيح ذلك علاجاً مستهدفاً وفعالاً يسرّع الشفاء ويحمي بصرك.
الصورة التوضيحية المرتبطة بهذا التحليل